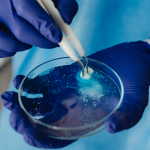
Galenica: in vigore nuovi divieti

News
AVVISO DI SELEZIONE PUBBLICA PER TITOLI ED ESAMI PER L’ASSUNZIONE CON CONTRATTO A TEMPO INDETERMINATO
Avviso-di-selezione-pubblica-per-farmacista-collaboratoreDownload Allegato-di-domandaDownload
“COMMESSO DI FARMACIA” (IMPIEGATO 5° Liv. CCNL Assofarm 2022-24) FULL-TIME (40 ORE) A TEMPO INDETERMINATO
Allegato-1_COMMESSO_FULLTIME_40ORE_FANDownload Disciplinare_bando_FULLTIME-COMMESSO-FAN_20012024Download
Regione Emilia-Romagna ha bandito il concorso
27.4.2023-News-concorso-Regione-Emilia-RomagnaDownload
Avviso di selezione pubblica per direttore di farmacia
Società partecipata del Comune di Velletri e che ha in gestione le quattro...
Popolari
DECALOGO SUL CORONAVIRUS Ministero Salute
L’Istituto Superiore di Sanità ed il Ministero della Salute hanno messo a punto
un Decalogo sul coronavirus, con l’adesione degli Ordini delle professioni...
La cellulite
La cellulite è un disturbo dell' ipoderma un tessuto di natura adiposa che si trova al di sotto del derma e che costituisce...
Più Letti
OMEOPATIA cos’è e come funziona
CHE COS'E' L'OMEOPATIAL' omeopatia, dal greco ómoioV = simile e πατóς = malattia, è una metodica medica basata sul principio della similitudineed utilizza le sostanze terapeutiche a...
Conservazione e scadenza dei farmaci
Che cos'è la data di scadenza?La scadenza indica la data entro la quale è possibile utilizzare il medicinale.Dove si legge?La data di...
Alimentazione
IntroduzioneAlimenti, principi nutrienti e funzioni principali Si definisce alimento qualsiasi sostanza che sia in grado di esercitare una o...
La febbre nel Bambino
- somministrare l'antipiretico quando la temperatura supera i 38,5 °C (o 37,5 - 38 °C in caso di bambini da 3 mesi...
La cellulite
La cellulite è un disturbo dell' ipoderma un tessuto di natura adiposa che si trova al di sotto del derma e che costituisce...
FITOTERAPIA
Fitoterapia, omeopatia, naturopatia, agopuntura, medicina ayurvedica, ecc., stanno assumendo in questi ultimi anni sempre maggiore importanza, riscuotendo vivo interesse su buona parte della...
Uso pericoloso dell’alcol etilico denaturato
Il Reparto Grandi Ustionati e il Centro di Documentazione ed InformazioneBiomedica dell’A.O.R.N. hanno predisposto una locandinaper illustrare la pericolosità dell’alcool denaturato.
L’armadietto farmaceutico
E' difficile fare un elenco esauriente dei farmaci da tenere in casa perché si dovrebbe tener conto anche di particolari esigenze terapeutiche...
Le Infezioni|Farmacisti in pillole
FARMACISTI IN PILLOLE è la nuova rubrica nata dalla collaborazione tra l'Ordine dei Farmacisti della provincia di Latina e...
Novità
“Croce Stella Italiana” – Richiesta collaborazione per emergenza Covid-19
L’Associazione di Volontariato “CROCE STELLA ITALIANA”, si avvale di professionisti Sanitari e non Sanitari, Medici Specialisti, tutti formati secondo le Normative vigenti....
I Farmacisti di Fondi premiati per il lavoro svolto durante la pandemia
Il Consiglio Direttivo ed il Collegio dei Revisori si congratulano con i Farmacisti di Fondi premiati dal Comune di Fondi per l'impegno...
Galenica: in vigore nuovi divieti
Sono in vigore i divieti di preparazioni in farmacia di galenici a base di steroidi anabolizzanti androgeni, di preparati dimagranti con estratto di Citrus...
Rubriche
Disturbi digestivi
(gonfiore, bruciore, dispepsia...)- evitare pasti troppo abbondanti- non coricarsi mai (né afflosciarsi in poltrona) subito dopo aver mangiato- svolgere regolarmente attività fisica-...
Alimentazione
Integratori, mercato in crescita. Farmacia canale di riferimento
Integratori, mercato in buona salute. Farmacia canale di riferimento, Gdo in crescita Integratori alimentari, il mercato si attesta su buoni livelli,...